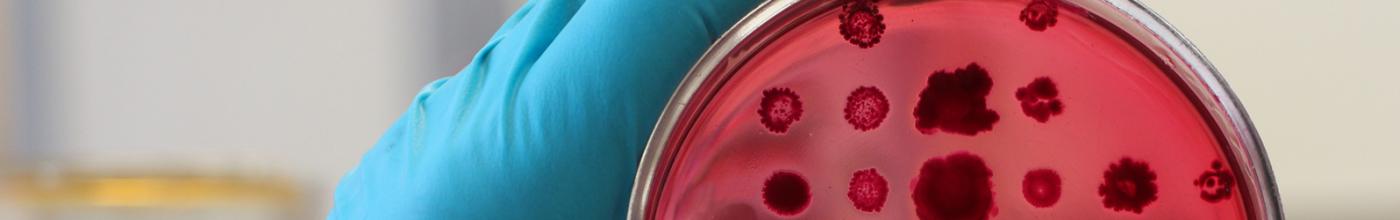

Image:
Conference Organising Committee (COC): Anusha Hettiaratchi, Carmel Quinn, Cassandra Griffin, Catherine Kennedy, Chris Gorman, Georget Reaiche, Helen Tsimiklis, Leanne Wallace, Louise Ludlow, Ussha Pillai
Seminar Series Organising Committee (SSOC): Beth Caruana, Chris Gorman, Georget Reaiche, Helen Tsimiklis, Jennie Hui, Louise Ludlow, Samantha Higgins
ABNA Exchange: Anusha Hettiaratchi, Carmel Quinn, Cassandra Griffin, Emma Dalziell, Georget Reaiche, Louise Ludlow
Website & Data Integration: Beth Caruana, Cassandra Griffin, Catherine Kennedy, Emma Dalziell, Georget Reaiche, Helen Tsimiklis, Louise Ludlow, Samantha Higgins, Ussha Pillai